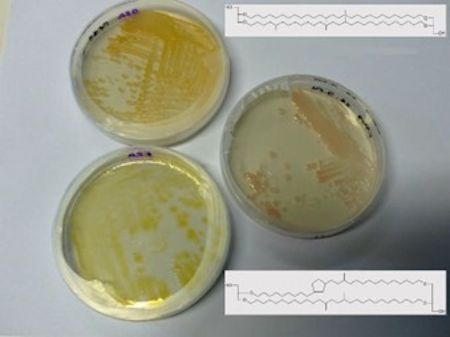

Approches Métabolomiques pour l’Étude des COLorants naturels
Algorithme de Reconnaissance et de Classification automatiques de la maçonnerie historique
Classement des archives associatives de l’Association Espéranto-France
Formulation de consolidants BIOsourcés pour REMédier à la fragilité des [...]
Bleu de Prusse : Procédés et ChimiE
Pratiques d’exploitation du bois dans la vallée de Zeravshan à [...]
Les Ethers de Glycérol comme marqueurs palEoenvironnementaux : identification de [...]
Patrimoine imprimé éphémère : des métadonnées d’éphémères à l’exploration des [...]
Etudes du vieillissement artificiel des liants protéiques des peintures murales
Étude des MEcanismes physico-chimiques de séchage de Peintures à l’Huile [...]
Détermination de l’ORigine biologique de la Nacre patrimoniale par l’Etude [...]
Analyse sédimentologique et malacologique de la séquence lœssique de Champagne‐sur‐Oise [...]
Reconstitution de l’évolution thermique de l’Océan Indien au cours du Paléogène
Caractériser l’origine des tortues d’Hermann dans le site paléolithique moyen [...]